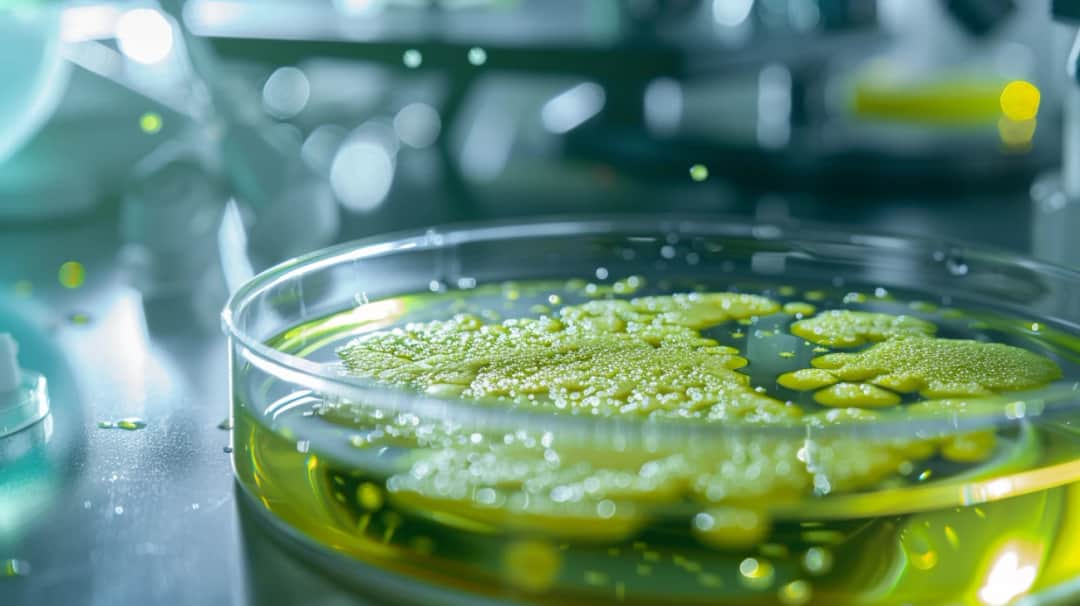
Clostridium difficile - groźne objawy zakażenia bakterią
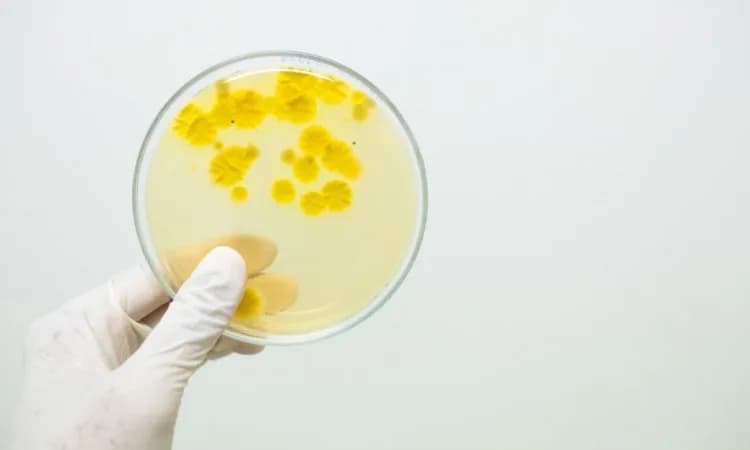
Bakterie w moczu - co oznacza wynik "bardzo liczne"?

Odkryj przyczyny ciągłych wzdęć i bólu brzucha - od nietolerancji pokarmowych po poważniejsze schorzenia. Dowiedz się, jak zdiagnozować problem i skutecznie złagodzić objawy.
Jestem założycielem i głównym autorem portalu o zdrowiu, który powstał z mojej pasji do medycyny i zdrowego stylu życia. Jako wykwalifikowany dietetyk z wieloletnim doświadczeniem, postanowiłem dzielić się wiedzą, która pomaga ludziom żyć pełniej i zdrowiej. Moja misja to dostarczanie rzetelnych, opartych na badaniach informacji o żywieniu, fitnessie i zdrowiu psychicznym. Wierzę, że każdy ma prawo do dostępu do wiedzy, która może znacząco poprawić jakość życia. Dążę do tego, by mój portal był miejscem, gdzie czytelnicy znajdą praktyczne porady, inspiracje oraz wsparcie w dążeniu do lepszego zdrowia.

Odkryj przyczyny ciągłych wzdęć i bólu brzucha - od nietolerancji pokarmowych po poważniejsze schorzenia. Dowiedz się, jak zdiagnozować problem i skutecznie złagodzić objawy.

Odkryj charakterystyczne objawy różnych chorób układowych, w tym chorób układu oddechowego, krążenia, nerek oraz wątroby. Sprawdź, na jakie niepokojące sygnały zwracać uwagę.

Czy zmagasz się z uporczywym uczuciem zmęczenia i osłabienia organizmu? Odkryj przyczyny chronicznego zmęczenia, objawy oraz sposoby na walkę z tym niepokojącym stanem

Odkryj przyczyny, objawy i skuteczne metody leczenia chorób immunosupresyjnych. Poznaj czynniki ryzyka i dowiedz się, jak chronić swój układ odpornościowy.

Poznaj kluczowe różnice między chorobami bakteryjnymi a wirusowymi, ich charakterystykę, objawy i metody leczenia. Dowiedz się, jak skutecznie zapobiegać tym zmaganiom zdrowotnym.
Clostridium difficile objawy to groźne infekcje jelitowe. Poznaj przyczyny i czynniki ryzyka zakażenia tą bakterią, charakterystyczne objawy oraz sposoby leczenia.

Dowiedz się wszystkiego o chorobach stawów – ich przyczynach, objawach i leczeniu. Przeczytaj o reumatoidalnym zapaleniu stawów, osteoartrozie, dnie moczanowej i innych chorobach stawów. Zapobiegaj problemom i utrzymuj zdrowie swoich stawów.

Odkryj, jakie produkty musisz bezwzględnie wyeliminować z diety przy celiakii czego nie jeść, aby uniknąć nieprzyjemnych objawów i komplikacji zdrowotnych

Czy zmagasz się z uporczywymi bólami brzucha, wzdęciami czy zaburzeniami wypróżnień? To mogą być niepokojące chore jelita objawy sygnalizujące poważniejszy problem. Dowiedz się o przyczynach i leczeniu tych dolegliwości.
Poznaj charakterystyczne candida objawy, takie jak zaczerwienienia skóry, naloty w jamie ustnej, bóle brzucha czy upławy. Sprawdź, jakie dolegliwości mogą sygnalizować zakażenie grzybicą candida.